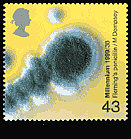
Alexander Fleming mould in petri dish.

Alexander Fleming discovered penicillin in the famous "mould in petri dish experiment" in 1928. Fleming realized that the mould in his petri dish was producing a substance that was killing the bacteria, and named it penicillin. The full capabilities of penicillin were not officially noticed until 1940 by the two British scientists Baron Howard Florey (see stamp issued by Australia) and Ernst Boris Chain the two men that he shared the Nobel Prize with (in 1945).
![]()
|